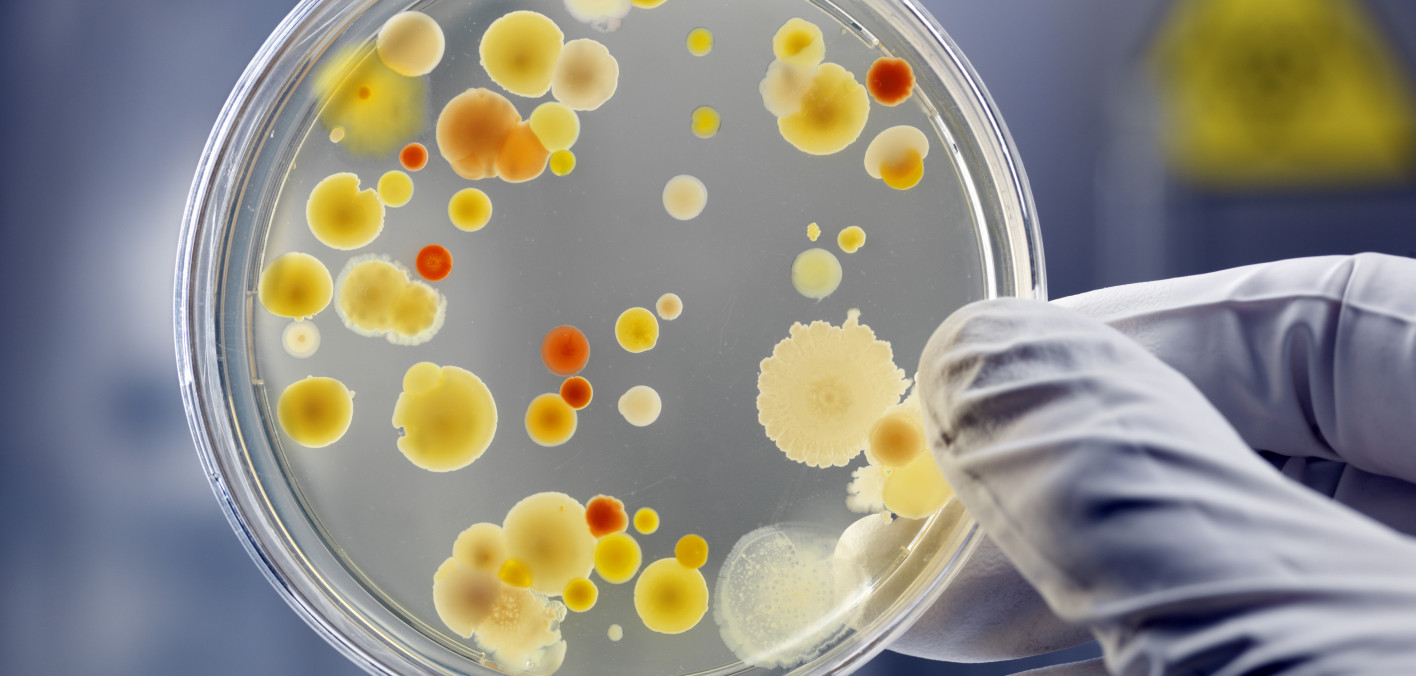
Book Review: The Mixed Blessing of Antibiotics

Read the latest news from regional and global sources, presenting different voices and perspectives.

October 27, 1492: When Columbus Reached Cuba, A Turning Point in Caribbean History
On October 27, 1492, Christopher Columbus reached the shores of Cuba, believing he had arrived in Asia. More than five centuries later, the island reflects on that moment as the beginning of a long and complex transformation. Cuba marks October 27...


How Little We Really Know About What Trump Is Up to in Latin America
A lot of things happened. Here are some of the things. This is TPM’s Morning Memo. US Strikes Extend to Pacific By its own admission, the Trump administration has expanded its lawless attacks on supposed drug-smuggling boats from the Caribbean to...

Louvre heist leaves a cultural wound that may turn French crown jewels into legend
The robbery at the Louvre has done what no marketing campaign ever could: It has catapulted France's dusty crown jewels — long admired at home, little known abroad — to global fame. One week on, the country is still wounded by the breach to its...


Hew Locke: Passages at Yale Center for British Art
NEW HAVEN – Three ships are sailing through the lobby of the Yale Center for British Art. Suspended from skylights in the four-story atrium, the large-scale sculptures are decked out with doll-house precision: cabins, hand-stitched sails,...


Make your own Halloween treats on this chocolatey SoFlo factory tour
Chocolate is a Halloween staple. But have you ever wondered what goes into making that delicious, ooey, gooey, melty goodness? Well — wonder no more! Because one SoFlo chocolate shop is serving up the ultimate spooktacular experience. You don’t...


My daughter and I were amazed by our ocean cruise in South America
We asked Star readers to tell us about trips they have taken and to share their experience and advice: Where South America When March 2023 Trip rating 5/5 What inspired you to take this trip? My daughter and I enjoyed an amazing ocean cruise in...


Trump Shrinks Refugee Inflow to 7,500 for 2026, Includes White South Africans
President Donald Trump is shrinking the inflow of refugees down to 7,500 refugees in 2026, which will help ordinary Americans earn higher wages from employers and also afford better housing. The 7,500 number, however, was furiously denounced by...


Federal workers clamor for shutdown resolution and Jamaica braces for historic storm: Morning Rundown
In today’s newsletter: Federal workers clamor for an end to the shutdown as they go without pay. The United States and China are expected to reach a trade deal, a top official says. And Jamaica braces for catastrophic Hurricane Melissa. Here’s...


Kenderson Noray presents Rhythm of My Heart at Horizons Art Gallery
Features Newsday 3 Hrs Ago Savannah Poui - Horizons Art Gallery presents Rhythm of My Heart, the latest solo exhibition by Kenderson Noray, one of Trinidad and Tobago’s well-loved contemporary artists. Kenderson Noray - A media release said, this...

Book Review: The Mixed Blessing of Antibiotics
The Sackler family, owner of Purdue Pharmaceuticals, rose to infamy after investigations and lawsuits around their role in America’s opioid crisis began piling up in the 2000s. By advertising to doctors — and lying about the risks of addiction —...


Today in History: October 27, ‘Curse of the Bambino’ reversed
Today is Monday, Oct. 27, the 300th day of 2025. There are 65 days left in the year. Today in history: On Oct. 27, 2004, the Boston Red Sox won their first World Series since 1918, sweeping the St. Louis Cardinals in four games. The team’s 86-year...

AEC BISHOPS CALL FOR PEACE & REGIONAL STABILITY IN THE SOUTHERN CARIBBEAN
The Bishops of the Antilles Episcopal Conference view with grave concern the recent build-up of naval and other military assets in the Southern Caribbean, and the potential implications this poses for the socio-economic, political, and...


Auction of works of art in Ecuador in solidarity with Cuba
The proceeds from the auction of the works will be used to purchase medical supplies for the Caribbean nation. Auction of works of art in solidarity with Cuba. Photo courtesy of Pilar Bustos October 26, 2025 Hour: 9:07 pm Latin American artists...

Milei scores historic win in Argentina midterms, tightens grip on Congress
Juan Pablo Villasmil of a Center for a Secure, Free Society and Dissident Project founder Daniel Di Martino react to the U.S.’ rescue of Venezuelan opposition members and the Trump administration’s pressure on the Maduro regime. NEWYou can now...


Biennale Of Sydney Announces Further Artists, Project Highlights And Initial Programming For 2026 Edition: Rememory
Press Release – Biennale of Sydney Announced today are an additional 16 artists and collectives for the 2026 edition, bringing the current number to 53 with a full list to be announced in the coming months. The Biennale of Sydney has today...


Guyana’s eco-tourism sector rooted in Indigenous heritage – Minister Rodrigues
GUYANA is not just making a mark in the eco-tourism sector; it’s leaving a huge dent, one that places our country among the best eco-tourism nations in the world. It is rooted deeply in Indigenous heritage. Minister of Tourism, Industry and...


Prime Minister of Barbados speaks out against US military presence in the Caribbean.
U.S. military operations in the Caribbean raise concerns as they undermine the area’s position as a Zone of Peace, said Mia Mottley, Prime Minister of Barbados Prime Minister of Barbados calls for stabilizing peace in the Caribbean. Photo: PL...


Drake surprises fans at dancehall star Vybz Kartel’s historic first Canadian show
TORONTO – When Drake was a teenager, he’d stand outside Toronto’s long-gone Escape Nightclub handing out flyers just to get inside and lose himself in Vybz Kartel’s music. On Sunday night, he came full circle, recalling that memory on stage as he...


U.S. weighing airstrikes on Venezuelan military sites linked to drug trafficking – WSJ
The Trump administration is evaluating potential airstrikes in Venezuela that would target military-run facilities allegedly used for drug trafficking, according to The Wall Street Journal. Officials told the WSJ that the list of targets includes...


Air Peace Marks Historic Abuja–Heathrow Launch, Strengthens Nigeria’s Global Aviation Footprint
October 26, (THEWILL) — Nigeria’s leading carrier, Air Peace Limited, has officially launched its maiden direct flight from Abuja to London Heathrow Airport, marking a major milestone in the country’s aviation history and strengthening its...

